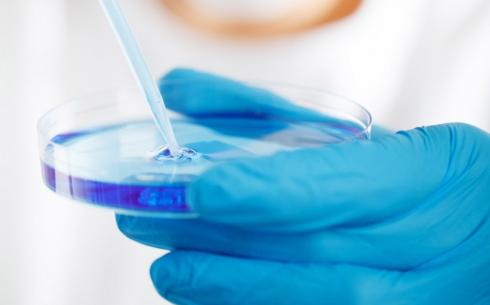

MEDIA
bg-none
NEWS CATEGORY

Photo Credit: Unsplash
- Innovation & Technology
三星窺準用家需求 擬拓移動通訊生態系統
29/09/2023
In an article by Prof. Erwin HUANG, Adjunct Professor of the Division of Integrative System and Design (ISD), he commented on Samsung’s efforts to expand its mobile communication ecosystem in response to users’ demands.

Photo Credit: Pexels

Photo Credit: Pexels
- Innovation & Technology
蘇州高新區(深圳)產業創新合作對接會舉行 26個項目集中簽約
28/09/2023
Prof. Pan HUI, Chair Professor of the Division of Emerging Interdisciplinary Areas (EMIA), spoke at the 2023 Suzhou New District Industrial Innovation Cooperation Conference on 27 Sept, 2023. He hoped that his team’s research could support the Suzhou New District to explore the cutting-edge information technology in the metaverse.

Photo Credit: Unsplash
- Environment & Sustainability
How Hong Kong can prepare for the next freak rainstorm
28/09/2023
In an article by Prof. Chi Ming SHUN, Adjunct Professor of the Division of Environment and Sustainability (ENVR), he commented on how Hong Kong can prepare for the next freak rainstorm by upgrading its flood defences and thoroughly assessing climate risk

Division of Integrative System and Design (ISD)
- Innovation & Technology
科大學生首創3D打印月餅
28/09/2023
Led by Prof. Mitch LI, Assistant Professor of the Division of Integrative System and Design (ISD), a group of ISD PhD students produced Hong Kong's first batch of 3D printed mooncakes with the HKUST logo using the 3D food printer they designed. The printer can finish producing a mooncake with tailored emblem on it in just 10 minutes.
星島日報網
科大學生首創3D打印月餅
星島網
科大學生首創3D打印月餅
頭條日報網
科大學生首創3D打印月餅
明報新聞網
科大3D打印月餅 10分鐘製成
華富財經 - 中文版
科大學生3D打印製作月餅慶中秋
匯港通訊
科大學生3D打印製作月餅慶中秋
大紀元時報 香港
科大生3D打印月餅慶中秋
信報 - 財經版
3D打印月餅10分鐘食得
大公網
月滿中秋/香江明月夜 細味中秋時
大公文匯網
月滿中秋/香江明月夜 細味中秋時
大公文匯網
香港仔時評|應提倡綠色簡約中秋節
星島日報網
科大學生首創3D打印月餅
星島網
科大學生首創3D打印月餅
頭條日報網
科大學生首創3D打印月餅
明報新聞網
科大3D打印月餅 10分鐘製成
華富財經 - 中文版
科大學生3D打印製作月餅慶中秋
匯港通訊
科大學生3D打印製作月餅慶中秋
大紀元時報 香港
科大生3D打印月餅慶中秋
信報 - 財經版
3D打印月餅10分鐘食得
大公網
月滿中秋/香江明月夜 細味中秋時
大公文匯網
月滿中秋/香江明月夜 細味中秋時
大公文匯網
香港仔時評|應提倡綠色簡約中秋節

Photo Credit: Unsplash
- Innovation & Technology
Bumpy road ahead as Hong Kong strives to regain chips crown
26/09/2023
In an article on the challenges faced by HK’s chips industry, Prof. Chi Ying TSUI, Head of the Division of Integrative System and Design (ISD), said that efforts to boost the chips industry have to be matched by sustained programs in training, retaining, and wooing semiconductor talents. He added that some HKUST graduates have left HK due to poor career prospects, but the supply of talents will not be a problem if there are enough opportunities for research and development.
China Daily - Global
Bumpy road ahead as Hong Kong strives to regain chips crown
China Daily - Global
Bumpy road ahead as Hong Kong strives to regain chips crown

Photo Credit: Pexels
- Innovation & Technology
他山之石/华为创科体系对香港的启发
25/09/2023
A study by Prof. Yan XU, Professor of the Division of Public Policy (PPOL), on the obstacles faced by companies in implementing open innovation policies in 2020 was cited in a column article on Huawei’s development and its implication to HK’s I&T ecosystem.

Photo Credit: Unsplash
- Innovation & Technology
蘋果生態系統挑戰者
22/09/2023
In a column article by Prof. Erwin HUANG, Adjunct Professor of the Division of Integrative System and Design (ISD), he discussed the challenges faced by Apple's iOS ecosystem as Android system companies have united to challenge Apple.

Photo Credit: Pixabay
- Business & Economy
China’s Economic Malaise Was Perfectly Predictable
20/09/2023
In an article by Prof. Donald LOW, Professor of Practice in Public Policy of the Division of Public Policy (PPOL), he discussed the current economic challenges in China and analyzed possible scenarios for its future. He suggested that fiscal policy and social reforms could stimulate domestic demand and reduce inequality.
The Diplomat
China’s Economic Malaise Was Perfectly Predictable
The Diplomat
China’s Economic Malaise Was Perfectly Predictable

Photo Credit: Unsplash
- Environment & Sustainability
Realizing true cost of sustainability
15/09/2023
In an article by Prof. Michael EDESESS, Adjunct Associate Professor of the Division of Environment and Sustainability (ENVR), he discussed the true cost of sustainability and emphasized that the path to full climate protection must involve science and tech, not just politics and finance.
China Daily - HK
Realizing true cost of sustainability
China Daily - HK
Realizing true cost of sustainability

Photo Credit: Pixabay
- Environment & Sustainability
Generations Y and Z urge the maritime industry to make human sustainability a strategic priority
29/08/2022
Prof. Christine LOH, Chief Development Strategist of the Division of Environment & Sustainability (ENVR),said at a maritime forum that young thought leaders in the maritime industry have strong visions of what it takes to attract a broad pool of talent.

Photo Credit: Pixabay
- Innovation & Technology
APRU MetaGame Conference 2022 Successfully Concludes in Hong Kong With Academics Pushing New Ideas on the Application of Esports in Education
01/09/2022
Prof. Pan HUI, Chair Professor of the Division of Emerging Interdisciplinary Areas (EMIA), spoke at the 3rd APRU MetaGame Conference hosted by Cyberport and in partnership with HKUST, encouraging the use of new technological tools to enhance the learning experience of students.
Pittsburgh Post-Gazette
APRU MetaGame Conference 2022 Successfully Concludes in Hong Kong With Academics Pushing New Ideas on the Application of Esports in Education
BizWire Express
APRU MetaGame Conference 2022 Successfully Concludes in Hong Kong With Academics Pushing New Ideas on the Application of Esports in Education
Business Wire India
APRU MetaGame Conference 2022 Successfully Concludes in Hong Kong With Academics Pushing New Ideas on the Application of Esports in Education
Line Today
科大數碼港合辦電競會議 Esports擬融入教育寓教於樂
Pittsburgh Post-Gazette
APRU MetaGame Conference 2022 Successfully Concludes in Hong Kong With Academics Pushing New Ideas on the Application of Esports in Education
BizWire Express
APRU MetaGame Conference 2022 Successfully Concludes in Hong Kong With Academics Pushing New Ideas on the Application of Esports in Education
Business Wire India
APRU MetaGame Conference 2022 Successfully Concludes in Hong Kong With Academics Pushing New Ideas on the Application of Esports in Education
Line Today
科大數碼港合辦電競會議 Esports擬融入教育寓教於樂

Photo Credit: Pixabay
- Innovation & Technology
VR雖屬輔助教學 但可提升80%記憶力?
01/09/2022
Prof. Pan HUI, Chair Professor of the Division of Emerging Interdisciplinary Areas (EMIA), shared in an interview about the advantages of VR in education and metaverse, which can make up for the limitation of traditional educational materials.

Photo Credit: Pixabay
- Business & Economy
- Public Policy
As China’s property crisis grows, can nationalisation help rebalance its economy?
04/09/2022
Prof. Donald LOW, Senior Lecturer of the Division of Public Policy (PPOL), wrote an article on the crisis in China’s property sector and how partial nationalisation of troubled assets and financial institutions helped restore financial stability and boost economic recovery.
Photo Credit: Pixabay
- Innovation & Technology
港科大(廣州)開學典禮抗疫"黑科技" 背後原來是這位"老員工"
07/09/2022
The smart anti-microbial coating developed by Prof. Joseph KWAN, Adjunct Professor of the Division of Environment and Sustainability (ENVR), and Prof. King Lun YEUNG, Professor of ENVR, was deployed on HKUST(GZ) campus for the inauguration ceremony last week. This feature article is about Prof. KWAN’s work on health and occupational safety in the past decades at HKUST and his current position as the Acting Head of HKUST(GZ)’s Office of General Coordination.

Photo Credit: Pixabay
- Innovation & Technology
GBA can play pivotal role in advancing national innovation
08/09/2022
Prof. Christine LOH, Chief Development Strategist of the Division of Environment and Sustainability (ENVR), wrote an article on how Hong Kong can help advance national innovation and assure its leadership role in the GBA and beyond.
China Daily - HK
GBA can play pivotal role in advancing national innovation
China Daily - HK
GBA can play pivotal role in advancing national innovation

Photo Credit: Pixabay
- World Relations
The West needs to brace for the Great Reset as new voices challenge the established world order
09/09/2022
Prof. Christine LOH, Chief Development Strategist of the Division of Environment and Sustainability (ENVR), said China’s rise and US failings are challenging the established world order as we have entered the Age of the Great Reset.

Photo Credit: Pixabay
- Public Policy
- Social Changes and Health
Disproportionately Focusing Vaccination Efforts on Least Advantaged Populations Benefits Everyone
13/09/2022
A research team co-led by Prof. Pan HUI, Chair Professor of the Division of Emerging Interdisciplinary Areas (EMIA), has revealed the key to breaking the dilemma of multiple ethical values from a data-intelligent epidemic model that can accurately predict COVID-19 curves in US metropolitan areas.
EurekAlert!
Disproportionately focusing vaccination efforts on the least advantaged populations benefits everyone
EurekAlert!
向弱勢群體傾斜的疫苗分配策略最能令社會受益
Today Postimes
Disproportionately Focusing Vaccination Efforts on Least Advantaged Populations Benefits Everyone
Mirage News
Disproportionately Focusing Vaccination Efforts on Least Advantaged Populations Benefits Everyone
Science Daily
Disproportionately focusing vaccination efforts on the least advantaged populations benefits everyone
EurekAlert!
Disproportionately focusing vaccination efforts on the least advantaged populations benefits everyone
EurekAlert!
向弱勢群體傾斜的疫苗分配策略最能令社會受益
Today Postimes
Disproportionately Focusing Vaccination Efforts on Least Advantaged Populations Benefits Everyone

Photo Credit: Pixabay
- Environment & Sustainability
- World Relations
China eyes sunny Central Asia for green energy, natural gas deals as need to bolster power supply grows more critical
15/09/2022
Prof. Laurence Laurencio DELINA, Assistant Professor of the Division of Environment and Sustainability (ENVR), raised his opinion on China making use of the Belt and Road Initiative to expand green-energy infrastructure in Central Asia. He said Central Asia can generate abundant solar and wind power because of its wide-open spaces and frequent sunny weather, adding that China is well positioned to support Central Asian countries with related technology.

Photo Credit: Pixabay
- Environment & Sustainability
直擊綠色金融論壇 / 探討可持續發展
22/09/2022
Prof. Arthur LAU, Program Director of Environmental Management & Technology and Program Co-Director of Sustainable Green Finance explained the importance of interdisciplinary education and green finance at interviews of the Commercial Radio HK.
Commercial Radio HK
2022.09.22 - 直擊綠色金融論壇 (from 08:40)
Commercial Radio HK
2022.09.23 - 探討可持續發展 (from 05:20)
Commercial Radio HK
2022.09.22 - 直擊綠色金融論壇 (from 08:40)
Commercial Radio HK
2022.09.23 - 探討可持續發展 (from 05:20)